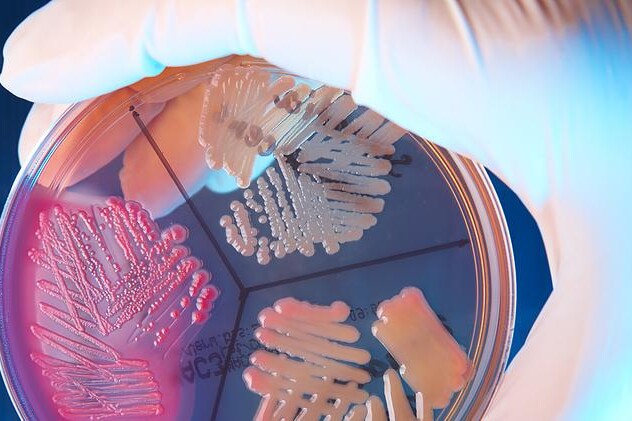
Bakteriální infekce

Dehydratace je nedostatek tekutin v těle. Ohrožuje především děti a staré lidi.

Bakterie se mohou rozdělit z hlediska infekčnosti do dvou skupin. První skupinu tvoří bakterie, které infekci vyvolají pokaždé. Druhou skupinu tvoří bakterie žijící v naší mikroflóře, které vyvolají infekci pouze při oslabeném imunitním systému. Bakteriální infekci můžeme různými způsoby předcházet. Mezi nejúčinnější prevence patří očkování.
Infekce neboli nákaza je proces, během kterého dojde k průniku choroboplodného organizmu (bakterie, viru, parazita, plísně) do těla člověka (nebo rostliny či zvířete), což způsobí reakci organizmu závislou na imunitním systému.
Bakteriální infekce jsou velmi častou příčinou neschopnosti na celém světě. Každý z nás se ročně setká buďto na sobě, nebo u někoho z blízkých s takovouto nákazou. Celý proces bychom mohli rozdělit do několika zásadních bodů, z nichž každý ovlivňuje to, zdali vůbec k nákaze dojde a pokud ano, jak se projeví a jaké budou následky. Bakterie se nacházejí všude kolem nás. Odhaduje se, že v jednom gramu půdy žije asi 40 milionů bakterií, ve vodě a vzduchu je jich méně. Obecně vzato lze říci, že těch bakterií, které pro nás jsou neškodné, ba dokonce prospěšné, je naprostá většina. Ty bakterie, které napadají člověka a způsobují u něj onemocnění, bychom mohli rozdělit na ty, které onemocnění způsobí vždy (bakterie tuberkulózy, moru, cholery apod.) a na ty, které onemocnění obyčejně nezpůsobují. Sem se řadí bakterie, které jsou součástí tzv. mikroflóry, čili přirozeně se vyskytují na kůži, ve střevě, v hltanu a dutině ústní. K infekci v tomto případě dojde, pokud je člověk oslaben, anebo se bakterie dostane ze svého běžného umístění někam jinam (Escherichia coli, Staphylococcus epidermidis, Streptococcus pyogenes aj.). Dalším činitelem ovlivňujícím vznik infekce je odolnost bakterií vůči prostředí. Pokud se totiž bakterie má přenést ze zvířete/prostředí/jiného člověka na daného jedince, musí být schopná přežít přenos. Proto se některé bakterie, které jsou citlivé vůči teplotě, tlaku, vlhkosti, záření apod., mohou přenášet pouze pohlavním stykem (Neisseria gonorhhoeae - původce kapavky), kdy je kontakt nejtěsnější. O něco více odolné se přenášejí vzduchem, dotekem, kapénkami, vodou, jídlem. Existují však bakterie, které jsou schopny v prostředí přežít i několik staletí (původce tetanu). Samostatnou skupinou jsou bakterie, které přenášejí krev sající členovci (komár, blecha, klíště). Nejčastější vstupní bránou infekce je kůže (především kožní infekce, kůže je dobrou překážkou, anebo infekce ran), dále nosní sliznice, sliznice hltanu, ucho, oko, pohlavní orgány. Pokud se bakterie do organizmu již dostane, má svoje způsoby, jak se tam množit. To, jestli se jí to podaří, záleží v té chvíli na funkčnosti obranného systému. Ten se aktivuje okamžitě po proniknutí do těla a zahajuje boj. Pokud je v dobrém stavu, nemusí se vůbec objevit příznaky nemoci, pokud však není v dobré kondici, anebo se s tímto onemocněním ani mu podobným ještě nesetkal, vytvoření obranných mechanismů trvá déle a příznaky nemoci se objevují. Bakteriální nákazy mohou být lehké, avšak patří sem i smrtelná onemocnění. Léčba je postavena na podávání antibiotik nemocnému buďto v tabletách, při těžším stavu pak do žíly. Zároveň může být podáno množství látek, které pomáhají v léčbě, v udržení dobrého stavu těla apod.
Rizikový je u bakteriálních infekcí pobyt v prostředí, které je zamořené, se zvířaty, která jsou nemocná či nemoc přenášejí, stejně jako s nemocnými a nemoc přenášejícími lidmi. Důležitá je prevence – předcházení vzniku nákaz posilováním obranyschopnosti cvičením, pohybem, zdravou stravou. U pohlavně přenosných onemocnění je potřeba se chránit kondomem, u onemocnění přenášených krev sajícími členovci používat repelenty a vhodné oblečení. Možností ochrany je také očkování, očkovací látky proti některým bakteriím jsou běžně na trhu. Následků nákaz je velké množství a záleží na všech výše popsaných činitelích. Nemusí se však vyskytovat žádné. Následkem, který vzniká vždy, je „vyškolení" obranyschopnosti, aby příště danou bakterii rozpoznala rychleji a odstranila ji dříve, než dojde k propuknutí nemoci. Vzniká vůči dané bakterii imunita.
Vznikem bakteriální nákazy jsme ohrožení prakticky každý den. Snažte se proto co nejlépe předcházet onemocnění. Pokud máte pocit, že již takovýmto onemocněním trpíte, navštivte prosím svého lékaře, který provede potřebná vyšetření a navrhne vám možnosti léčby.